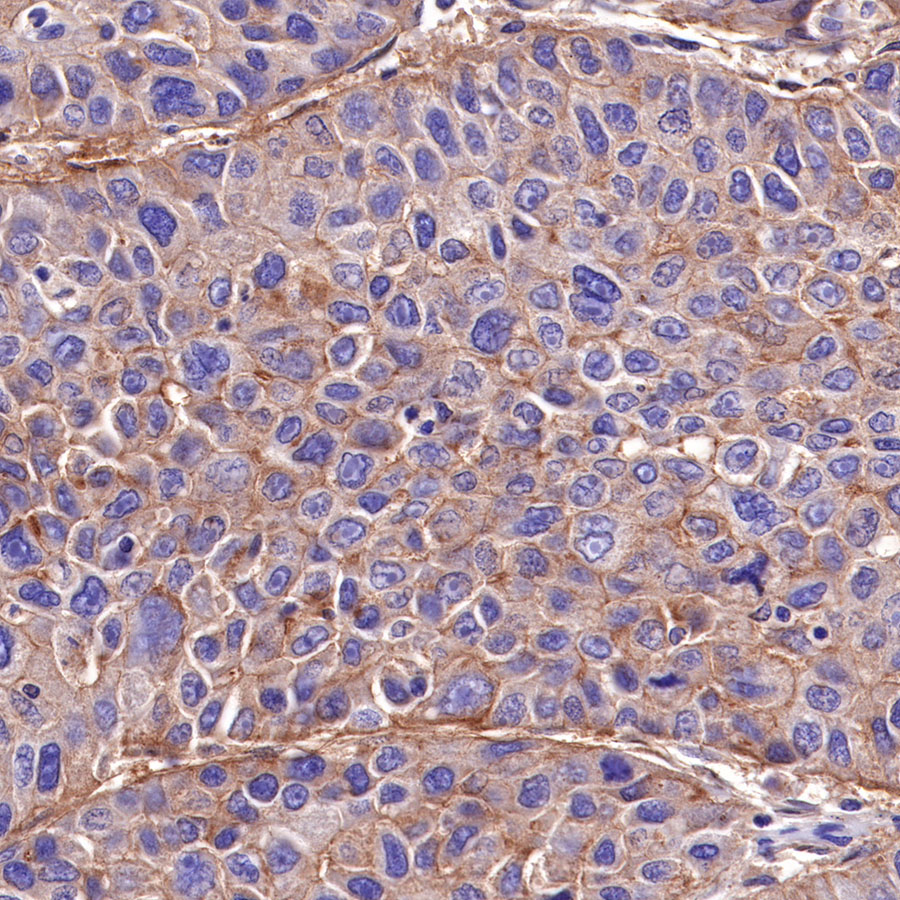
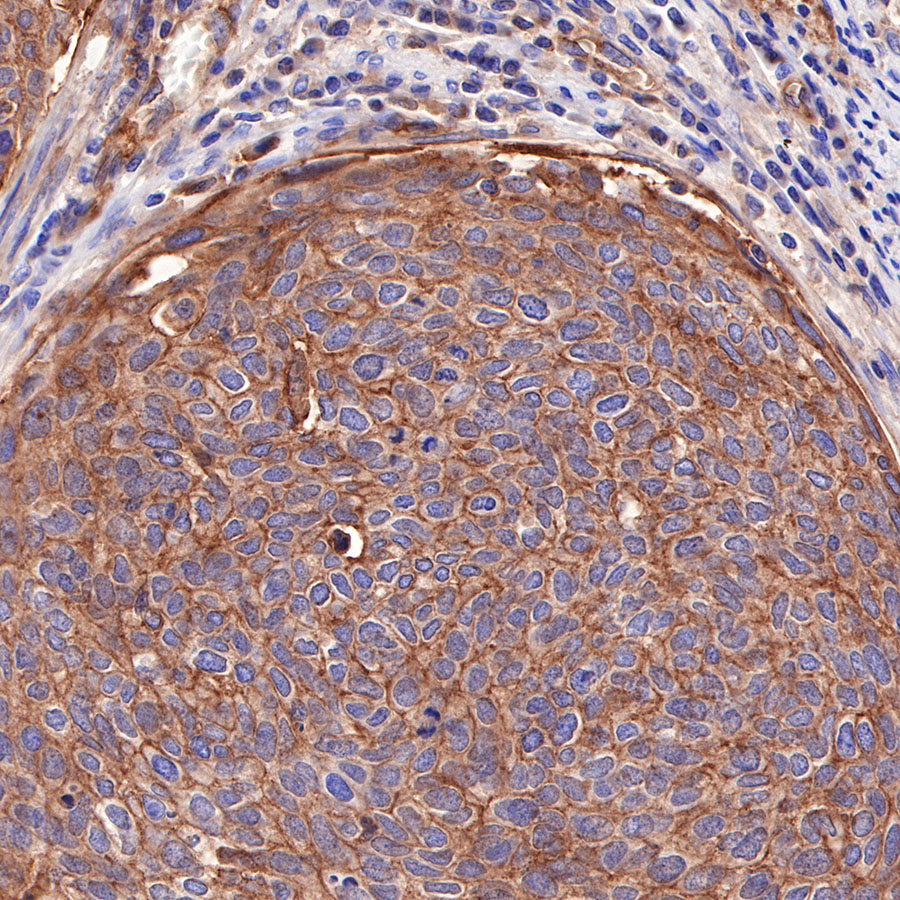
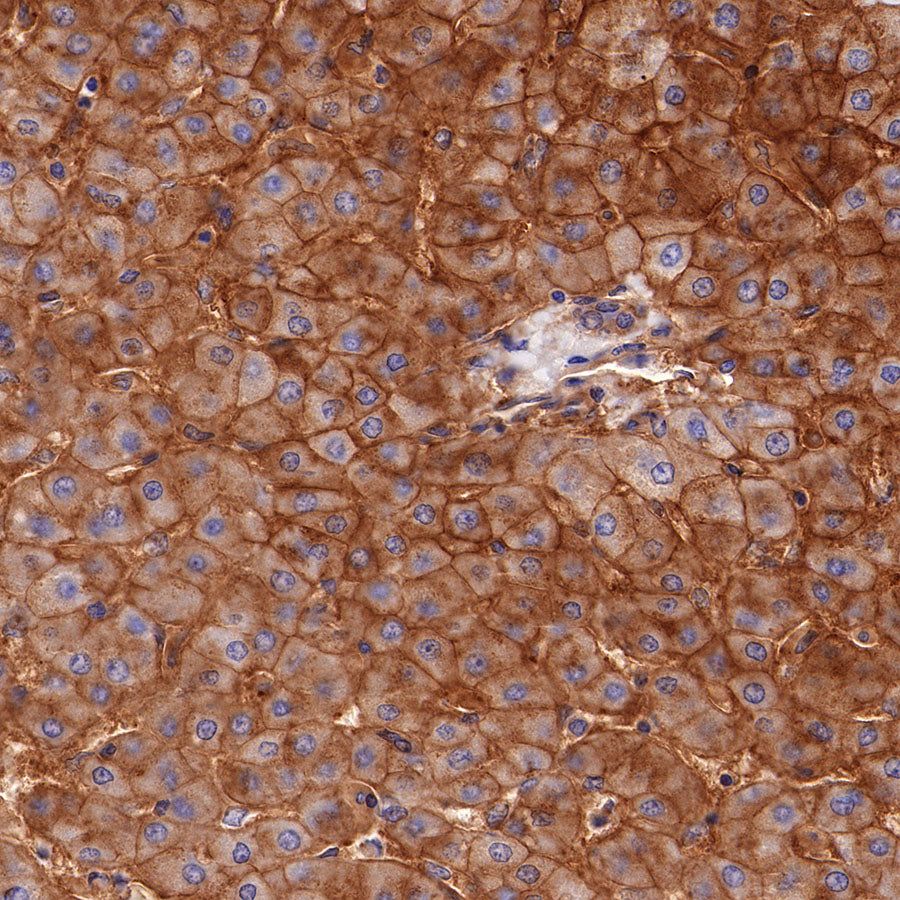
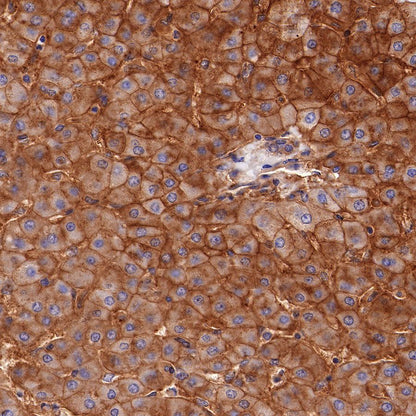
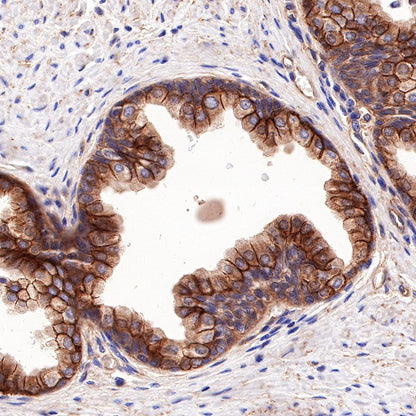
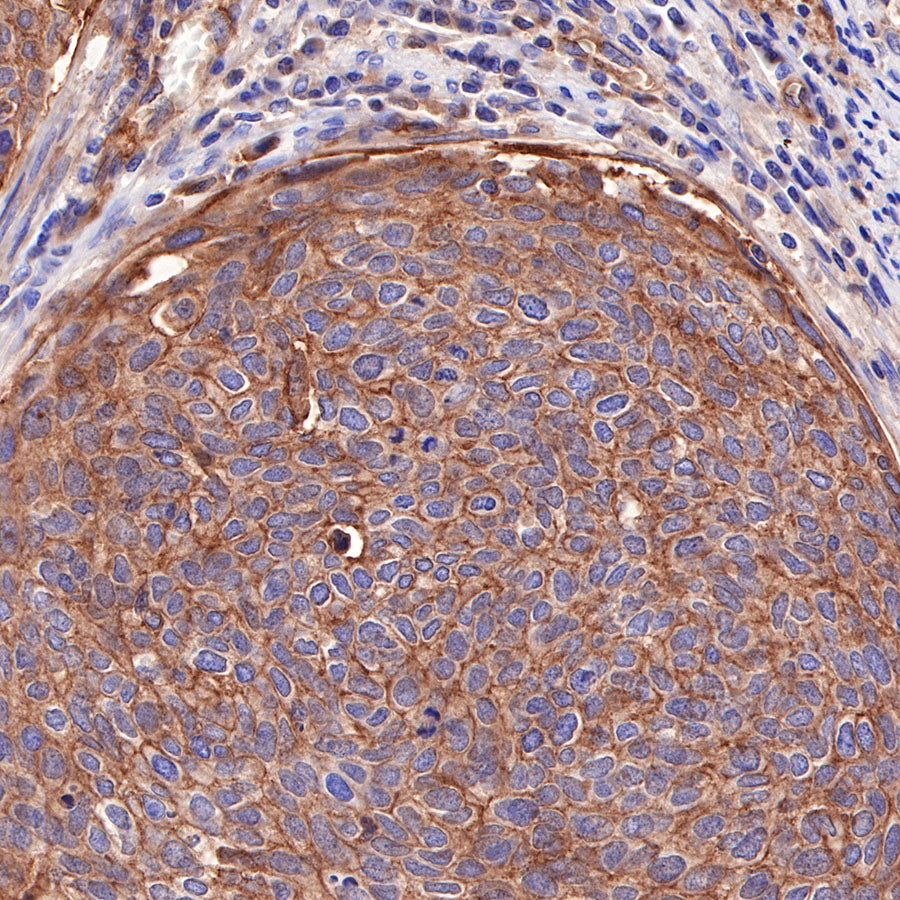
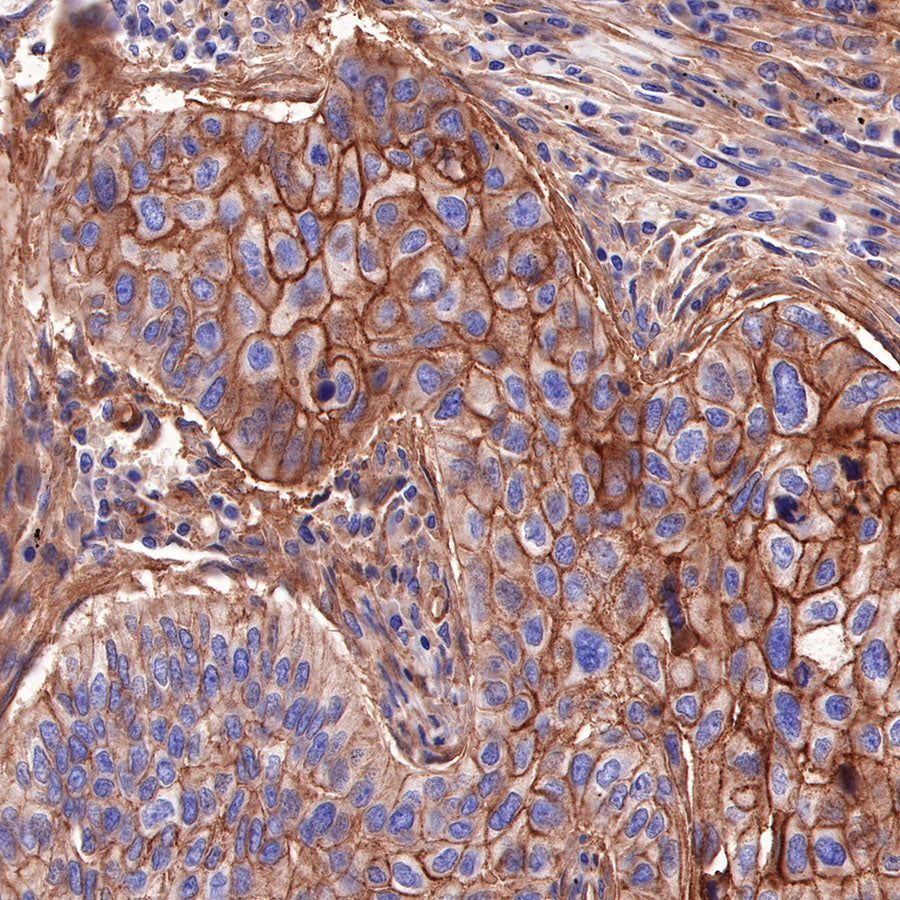

Product Specification
| Host |
Rabbit |
| Antigen |
CD155/PVR |
| Synonyms |
Poliovirus receptor, Nectin-like protein 5, NECL-5, PVS |
| Immunogen |
Recombinant Protein |
| Location |
Secreted, Cell membrane |
| Accession |
P15151 |
| Clone Number |
SDT-289-68 |
| Antibody Type |
Recombinant mAb |
| Application |
WB, IHC-P |
| Reactivity |
Hu |
| Purification |
Protein A |
| Concentration |
0.25 mg/ml |
| Physical Appearance |
Liquid |
| Storage Buffer |
PBS, 40% Glycerol, 0.05% BSA, 0.03% Proclin 300 |
| Stability & Storage |
12 months from date of receipt / reconstitution, -20 °C as supplied |
Dilution
| application |
dilution |
species |
| WB |
1:1000 |
null |
| IHC-P |
1:1000-1:2000 |
null |
Background
Poliovirus receptor (PVR, CD155), a member of the nectin-like family of proteins, is recently emerging as a promising target in immunotherapy that enhances the existing anti-tumor responses. Similar to other members of the family, PVR is involved in important cellular processes, such as adhesion, contact inhibition, migration, proliferation, and the immune response [PMID: 18648374]. PVR is dramatically overexpressed in several human malignancies, whereas its expression is low or absent in most healthy tissues [PMID: 10841575, PMID: 11454801, PMID: 15604290, PMID: 15536144, PMID: 19801517]. Consistent with PVR biology, its overexpression promotes tumor cell invasion, migration, and proliferation and is associated with a poor prognosis and enhanced tumor progression [PMID: 16322240, PMID: 17893876, PMID: 25743219, PMID: 25862891]. Simultaneously, PVR has a considerable immunoregulatory potential. It interacts with the (co)stimulatory receptor DNAM-1 and the inhibitory receptors TIGIT and CD96, resulting in either immune cell activation or inhibition, respectively [PMID: 28870470].